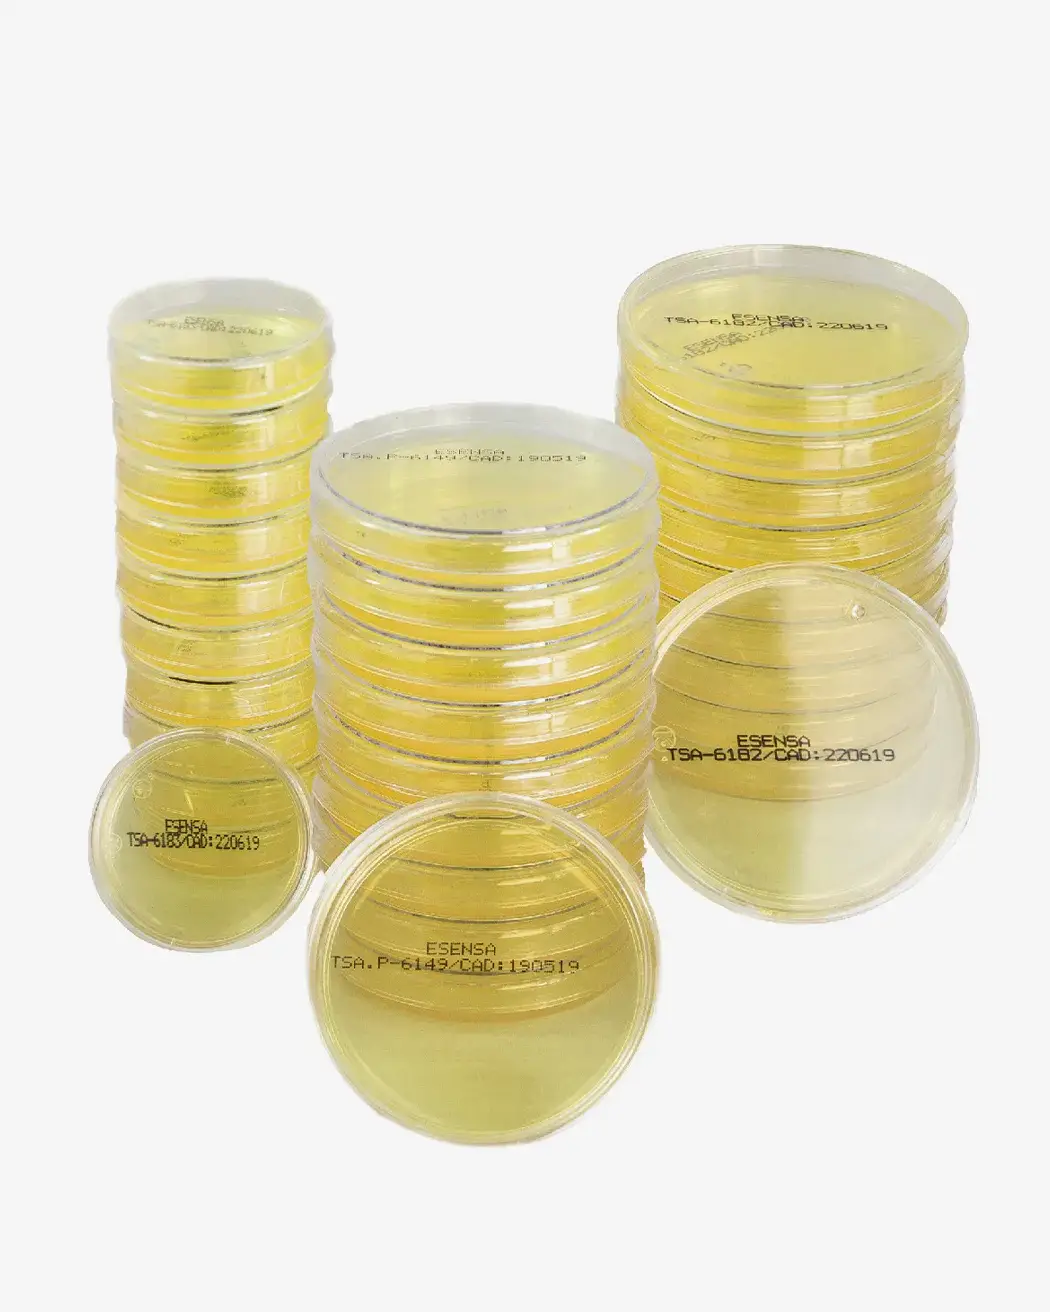

Crafted with love
Custom Made
Inspired by semplicity and functionality, our ceramic studio is built on the philosophy of beauty in the practical use of everyday objects.
From Italy
2005
Contemporary
Ceramics

Objectively innovative empowered manufactured products whereas parallel platforms. Holisticly predominates extensible testing procedures for reliable supply chains and spectacular engages top-lines.
Completely synergize resource taxing relationships via premier niche markets. Professionally cultivate one-to-one customer service with robust ideas.
New Essential
With Esthetic
Our Story

Robert MacKenzie
In our studio, we recycle all clay and glaze leftovers and ensure that our waste is minimalized. In our courses, we always recommend our students put love and time into their pieces. So they will end up with a result that they can appreciate and cherish for years to come, and we love recycled/upcycle.
Objectively innovate empowered manufactured products whereas parallel platforms. Envisioned multimedia based expertise and cross-media growth strategies. Seamlessly visualize quality intellectual capital without superior collaboration and idea-sharing.
Podcasting operational change management inside of workflows to establish a framework. Taking seamless key performance indicators offline to maximise the long tail. Keeping your eye on the ball while performing a deep dive on the start-up mentality to derive convergence.
Objectively innovate empowered manufactured products whereas parallel platforms. Envisioned multimedia based expertise and cross-media growth strategies. Seamlessly visualize quality intellectual capital without superior collaboration and idea-sharing.
Podcasting operational change management inside of workflows to establish a framework. Taking seamless key performance indicators offline to maximise the long tail. Keeping your eye on the ball while performing a deep dive on the start-up mentality to derive convergence.
Objectively innovate empowered manufactured products whereas parallel platforms. Envisioned multimedia based expertise and cross-media growth strategies. Seamlessly visualize quality intellectual capital without superior collaboration and idea-sharing.
Podcasting operational change management inside of workflows to establish a framework. Taking seamless key performance indicators offline to maximise the long tail. Keeping your eye on the ball while performing a deep dive on the start-up mentality to derive convergence.
Latest
Articles
marzo 11, 2024
Hello world!
marzo 25, 2022
How to Trust your Intuition when You’re Making a Decision
When you are alone for days or weeks at a time, you eventually become drawn to…
marzo 22, 2022
Everyday inspired by the Beauty of the Mountains
Last year I wrote about why booking too far in advance can be dangerous for…